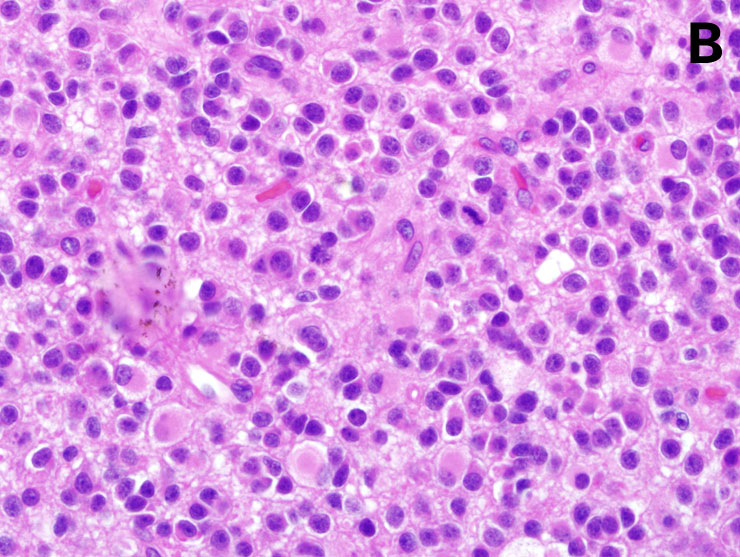

Novel diagnostic and therapeutic approaches to malignant glioma
DOI: https://doi.org/10.4414/smw.2011.13210
Summary
Glioblastomas (World Health Organisation (WHO) grade IV) and anaplastic gliomas (astrocytomas, oligoastrocytomas, oligodendrogliomas) (WHO grade III) are collectively referred to as malignant gliomas. The diagnosis of malignant glioma may be suspected based on clinical history and neuroimaging findings, but histological confirmation remains the diagnostic “gold standard”. Molecular markers such as 1p/19q codeletion and isocitrate dehydrogenase (IDH) mutation provide important diagnostic and prognostic information. O–methylguanylmethyltransferase (MGMT) promoter methylation is another favourable prognostic marker and predicts benefit from alkylating agent chemotherapy in glioblastoma. Additionally, the extent of neurosurgical resection is a prognostic factor. Radiotherapy of the involved brain region or chemotherapy using the alkylating agent, temozolomide, are common therapeutic options for patients with anaplastic glioma. In contrast, temozolomide plus radiotherapy is the standard of care for most patients with glioblastoma. The increasing population of elderly patients with glioblastoma represents a particular challenge, with surgery followed by radiotherapy as the standard of care. Contemporary clinical studies focus on the role of angiogenesis. Specifically, pivotal phase III studies exploring the antibody to vascular endothelial growth factor (VEGF), bevacizumab, and the αvβ3/5 antagonist, cilengitide, in the management of newly diagnosed glioblastoma have completed enrolment. Moreover, a broad spectrum of other experimental treatment approaches, including immunotherapy with vaccines against glioma-associated antigens, are currently being explored in phase I/II clinical trials.
Abbreviations:
EEG electroencephalography
EORTC European organization for research and treatment of cancer
FLAIR fluid-attenuated inversion recovery
HDAC histone deacetylase
IDH isocitrate dehydrogenase
MGMT O6–methylguanylmethyl-
transferase
MRI magnetic resonance imaging
PCR polymerase chain reaction
PET positron emission tomography
RTOG radiation therapy oncology group
SPECT single photon emission-computed tomography
Epidemiology and clinical presentation
The diagnosis and grading of primary brain tumours follows the World Health Organisation (WHO) classification [1]. The overall annual incidence of gliomas is in the range of 5–6/100,000 ( http://www.cbtrus.org ) (table 1). Anaplastic astrocytomas, anaplastic oligoastrocytomas and anaplastic oligodendrogliomas (WHO grade III), as well as glioblastomas (WHO grade IV), are collectively referred to as malignant gliomas, whereas WHO grade I and II gliomas are designated low-grade gliomas. Among the malignant gliomas, anaplastic gliomas have a much better prognosis than glioblastomas, and among the anaplastic gliomas the detection of an oligodendroglial component confers a better prognosis. Accordingly, for the definition of more homogenous populations, these tumours are no longer enrolled into the same clinical trials. The aetiology of most malignant gliomas remains unknown. Some hereditary syndromes are associated with an increased glioma risk, including Li-Fraumeni syndrome and neurofibromatosis types I and II. Moreover, exposure to irradiation in childhood has been linked to an increased risk for glioma development.
At the present time, screening for gliomas has no clinical relevance. This is because of the low incidence, the lack of sensitive biomarkers in plasma, and the observation that gliomas may develop apparently de novo within few weeks or months. Thus, the diagnosis is mainly based on neuroimaging in individuals suspected of harbouring an intracranial lesion which is performed because of clinical history (e.g. seizure, personality change or neurological deficits) confirmed by neurological examination or encephalography (EEG). Magnetic resonance imaging (MRI) is the method of choice to rule out or detect an intracranial neoplasm (figure 1). The diagnosis, treatment and follow-up of patients with malignant gliomas is an interdisciplinary challenge that is best met by specialised centres with dedicated brain tumour boards and interdisciplinary outpatient clinics.
Histology and molecular pathology
All lesions suggestive of primary brain tumours should be biopsied before therapeutic decisions are made. This includes elderly patients with large tumours for which no further treatment may be a reasonable strategy. The rationale for recommending a histological verification in all patients includes the risk of false diagnoses made by neuroimaging alone. Obtaining a definitive tissue diagnosis is important to reassure physicians, patients and relatives, even in situations where radiotherapy or chemotherapy are not considered viable options. The diagnosis of an anaplastic glioma (WHO grade III) as opposed to a grade II lesion is based on mitotic activity in the context of a glial neoplasm. Vascular proliferation and necrosis are important features that define WHO grade IV tumours (glioblastomas). The differentiation of mixed oligoastrocytomas from either pure astrocytomas or pure oligodendrogliomas has remained controversial [1] (figure 2).

Figure 1
MRI features of right fronto-temporal glioblastoma: T2–weighted MRI (left), T1–weighted MRI with contrast enhancement (middle) and amino acid (18F-ethyltyrosine) PET overlay (right) (courtesy: F. Kuhn, Zurich). On the left, a multifocal, irregular lesion with prominent oedema and mass effect on the lateral ventricle is depicted. In the middle, rim-like contrast enhancement around the necrotic core tumour lesion can be observed. On the right, the PET signal reflects hyper-metabolic areas around this necrotic lesion.
Currently, at least three molecular markers assume an important diagnostic, prognostic or predictive role in malignant gliomas [2] (figure 3): 1p/19q codeletion, MGMT promoter methylation and IDH-1/2 mutation. The combined loss of genetic material from chromosomes 1 and 19 is probably caused by unstable translocations and is tightly linked to gliomas with an oligodendroglial morphology [3, 4]. The 1p/19q codeletion is detected by fluorescent in situ hybridisation or microsatellite-polymerase chain reaction (PCR)-based assays for the detection of allelic losses, and confers a more favourable prognosis. MGMT promoter methylation is assessed by methylation-specific PCR of the promoter region and is thought to result in loss of MGMT protein, a DNA repair enzyme that counteracts alkylator-induced DNA damage. This molecular marker is not differentially distributed among various types of glioma, but stands out as a putative predictive marker for benefit from chemotherapy [5]. Mutations in the IDH genes, mainly IDH-1, can be detected by PCR and direct sequencing, and are very common in grade II and III gliomas but rare in glioblastomas [6, 7]. This indicates that most glioblastomas are biologically distinct tumours that are not related to typical lower grade precursor lesions [8]. The pathogenetic role of IDH mutations in gliomagenesis remains controversial, but may involve an altered, novel gain of function of mutant IDH enzymes which produce an oncometabolite, α-hydroxyglutarate. IDH mutations are prognostically favourable and almost never occur in elderly patients with malignant gliomas, partially explaining the negative prognostic impact of age in these patients [7]. Finally, specific antibodies to mutant IDHR132H have become a valuable diagnostic tool because such mutations are very common in grade II/III gliomas but absent, for example, in pilocytic astrocytomas or ependymomas [8].
Treatment of anaplastic glioma
Newly diagnosed disease
The classical treatment of newly diagnosed anaplastic glioma includes resection to the extent feasible, followed by radiotherapy (54–60 Gy in 1.8–2 Gy fractions) to the tumour region with a safety margin of 2–3 cm, depending on tumour location. Surgery in malignant glioma patients commonly aims at removing as much of the tumour as possible, without causing new neurological deficits. Biopsy may be the only option for multifocal tumours or tumours involving the corpus callosum. The role of chemotherapy in addition to radiotherapy has been addressed in various studies, but the results are inconclusive. In the past, anaplastic astrocytoma patients were included in the same trials as glioblastoma patients and the trials were not designed to confirm an advantage of combined modality treatment over radiotherapy alone. For instance, a large British trial examined combined procarbacin, CCNU (lomustin) and vincristin (PCV), albeit in an uncommon dosing regimen, and reported a median survival of 15 months with radiotherapy plus PCV versus 13 months with radiotherapy alone [9]. Based on several smaller studies in the 1990’s, with PCV given at recurrence after radiotherapy, both the European Organisation for Research and Treatment of Cancer (EORTC) and the Radiation Therapy Oncology Group (RTOG) in the USA and Canada explored the role of PCV either prior to radiotherapy (EORTC 26951) or after radiotherapy (RTOG 94–02) in anaplastic oligodendroglial tumours. Both studies showed that the addition of PCV to radiotherapy in newly diagnosed anaplastic oligodendroglial tumours prolonged progression-free survival, but not overall survival [10, 11]. Since the haematological toxicity from PCV was substantial, it was felt that adjuvant PCV should not be considered the standard of care for these tumours.



Figure 2
Morphological characteristics of malignant gliomas: A = anaplastic astrocytoma, B = anaplastic oligodendroglioma, C = glioblastoma (for details, see text) (courtesy: E. Rushing, Zurich). A shows a moderately cellular astrocytic tumour with mitoses and pleomorphic nuclei. B shows closely apposed tumour cells with round nuclei and perinuclear halos accompanied by mitoses typical of an anaplastic oligodendroglioma. C shows areas of necrosis and perinecrotic palisade formation characteristic of glioblastoma.
As an alternative to intensive treatment in the newly diagnosed setting, the German Neuro-Oncology Group (NOA) explored whether chemotherapy using PCV or temozolomide alone could substitute for radiotherapy alone in the treatment of newly diagnosed anaplastic glioma. The NOA-04 trial demonstrated no difference for progression-free or overall survival between these first-line treatments in anaplastic astrocytoma, oligoastrocytoma and oligodendroglioma. Of note, temozolomide was as effective as PCV, but better tolerated. Importantly, the median survival exceeded 70 months, which was favourable compared with historical databases. Most likely, this survival advantage indicates improved overall patterns of care rather than patient selection, given that 318 patients from many sites across Germany were enrolled in this trial [12]. NOA-04 also demonstrated, for the first time in a prospective manner, that anaplastic oligodendroglial tumours have a better prognosis than anaplastic pure astrocytic gliomas. Oligodendroglial and oligoastrocytic tumours shared the same more favourable course. Accordingly, the current recommendation for the management of anaplastic glioma patients is to use either radiotherapy or chemotherapy alone, but not combined modality treatment (table 2).
Analyses of the three randomised trials [10–12] established the prominent prognostic role of molecular markers in patients with anaplastic gliomas and revealed the following findings: the 1p/19q codeletion is strongly associated with oligodendroglial morphology and better outcome with either radiotherapy alone, chemotherapy alone or combined modality treatment [10–12]; MGMT promoter methylation predicts longer progression-free and overall survival independent of the type of genotoxic treatment [12, 13]; and IDH mutations are common in all types of anaplastic glioma and prognostically favourable independent of treatment, too [12, 14]. Accordingly, none of these markers is presently useful for choosing between radiotherapy, chemotherapy or combined modality treatment today [2].
Recurrent disease
The failure of adjuvant PCV added to radiotherapy to increase overall survival may result from the efficacy of the treatment for recurrent disease (e.g. PCV or temozolomide or both) when given as a salvage treatment at recurrence after radiotherapy. In fact, several treatment options are now available for patients with recurrent anaplastic glioma (table 2). The choice is mainly determined by the type of primary treatment, that means patients who have not been previously irradiated should receive radiotherapy at recurrence. Patients irradiated at diagnosis should receive alkylating agent chemotherapy, and considering the favourable safety and tolerability profile, this should mostly be temozolomide. Patients progressing after radiotherapy and one or two lines of alkylating agent chemotherapy may be treated with bevacizumab monotherapy [15, 16] or another experimental treatment strategy.
Current trials
The cooperative trial groups have agreed that future studies should take the difficulties in sub-classifying anaplastic gliomas by morphology alone into consideration, as well as the profound prognostic impact of molecular markers. Accordingly, the CATNON trial, in a 2x2 design, only enrols patients with anaplastic glioma without 1p/19q codeletion and examines the role of temozolomide added to radiotherapy. The CATNON arms include radiotherapy alone, radiotherapy plus concurrent temozolomide, radiotherapy plus adjuvant temozolomide, and radiotherapy plus concomitant and adjuvant temozolomide. Patients will be stratified for MGMT promoter methylation status. A companion protocol, CODEL, for 1p/19q-codeleted tumours will compare radiotherapy alone, chemotherapy alone and radiochemotherapy using temozolomide. This trial will thus combine features of NOA-04 [12] and the EORTC NCIC trial for glioblastoma (see below) [17].
|
Table 1: Malignant gliomas: epidemiology and outcome ( http://www.cbtrus.org ). |
|
|
Annual incidence per 100,000
|
Survival at 1 year (%)
|
Survival at 3 years (%)
|
Survival at 5 years (%)
|
| Anaplastic astrocytoma |
0.41 |
60.3 |
34.7 |
27.4 |
| Anaplastic oligodendroglioma |
0.12 |
79.9 |
59.6 |
49.4 |
| Glioblastoma |
3.19 |
34.6 |
7.3 |
4.8 |
|
Table 2: Current treatment options for malignant glioma patients. |
|
|
Newly diagnosed
|
Recurrence or progression
|
| Anaplastic astrocytoma WHO grade III |
Resection (or biopsy) and radiotherapy or temozolomidea,b (or radiotherapy plus temozolomidec) |
(Re-resection and) temozolomide or radiotherapy (or re-irradiation) or bevacizumab |
| Anaplastic oligodendroglioma and anaplastic oligoastrocytoma
WHO grade III |
Resection or biopsy and radiotherapy or temozolomidea,b (or radiotherapy plus temozolomidec) |
(Re-resection and) temozolomide or radiotherapy (or re-irradiation) or bevacizumab |
| Glioblastoma
WHO grade IV |
Resectiond (or biopsy) and radiotherapy and chemotherapy (temozolomide)e
|
(Re-resection and) chemotherapy (dose-intense temozolomide or nitrosourea) (or re-irradiation) or bevacizumabf
|
|
aNOA-04 trial [12]
bTemozolomide probably equieffective to nitrosoureas but better tolerated [12]
cexplored in the CATNON and CODEL trials
dStummer et al. [18]
eEORTC 26981–22981 NCIC CE.3 [17, 19]
fFriedman et al. [33], Kreisl et al. [34] |
Treatment of glioblastoma
Newly diagnosed disease
The standard of care for newly diagnosed glioblastoma includes surgical resection when feasible and involved-field radiotherapy to 54–60 Gy in 1.8–2 Gy fractions, similar to anaplastic glioma. The role of resection was confirmed by demonstrating that the increase in the rate of complete resections, aided by the fluorescent marker 5–aminolevulinic acid to delineate the tumour area under the surgical microscope, translated into improved progression-free survival at 6 months [18]. Although the impact of this trial has been challenged because the adjuvant treatment consisted of radiotherapy alone, and not radiotherapy plus temozolomide, which is the current standard of care [17], there is now little doubt that the extent of resection determines progression-free survival, degree of steroid dependence and, therefore, quality of life.



Figure 3
Molecular markers in malignant glioma. A: 1p/19q codeletion. Microsatellite-PCR-based analysis of allelic losses of 1p and 19q in an astrocytoma (WHO grade II) (A II) and an anaplastic oligodendroglioma (WHO grade III) (AO III). Losses of both markers are indicated by arrowheads in AO III, but not A II. B:
MGMT promoter methylation. Methylation-specific PCR for unmethylated (U) and methylated (M) promoter sequences in 5 glioblastoma samples, including the glioblastoma cell line A172 as a positive control for methylated and peripheral blood cells as a control for unmethylated promoter sequences, as well as water as a negative control. C:
IDH mutation. Grade II oligoastrocytoma, upper panels: HE staining, lower panels: IDH immunostaining, left panels: tumour centre, right panels: infiltration zone (Courtesy: J. Felsberg, Düsseldorf).
Glioblastoma patients aged 70 or less with a good performance status should be treated with radiotherapy and concomitant and adjuvant temozolomide [17, 19]. The benefit from chemotherapy is more prominent in younger patients, in particular, in patients with MGMT promoter methylation [19, 20]. Overall, there was an increase in median survival from 12.1 to 14.6 months, and of the 2 year survival rate from 11% to 27% in patients receiving temozolomide, and the 2 year survival rate approached 49% in temozolomide-treated patients with MGMT promoter methylation [19]. Since the introduction of temozolomide, the role of nitrosoureas given either systemically or locally in the form of wafers [21] has steadily declined.
The standard of care for the large population of elderly patients with glioblastoma is less well defined. Radiotherapy is superior to best supportive care [22] and can be administered in an accelerated fashion (40 Gy in 15 fractions) [23]. Whether temozolomide alone is equally effective as radiotherapy remains controversial. The preliminary report from the Nordic trial reported no difference [24], whereas the preliminary report from the NOA-08 trial failed to demonstrate non-inferiority of dose-dense TMZ alone versus radiotherapy alone [25]. A large prospective study of elderly glioblastoma patients from the German Glioma Network identified a strong predictive value of MGMT promoter methylation for benefit from temozolomide. Accordingly, the results from the Nordic trial and NOA-08 may only be adequately interpreted when data on the relationship between MGMT promoter methylation status and outcome become available [26].
Recurrent disease
Therapeutic options for patients with recurrent glioblastoma are steadily increasing, but standards of care are not well defined. A minority of patients, approximately 20–25%, may benefit from a second surgery and some patients are candidates for a second course of radiotherapy. Whether these are good options depends on the site and pattern of relapse as well as the interval from the prior treatment. Randomised trials seeking to prove the role of novel agents including the tyrosine kinase inhibitor, erlotinib [27], the protein kinase C-β inhibitor, enzastaurin [28], or the VEGF receptor inhibitor, cediranib [29], which were all negative, confirmed the limited activity of nitrosoureas in temozolomide-pretreated glioblastoma patients. Moreover, there is ongoing interest in determining the best mode of administration of a temozolomide “rechallenge” in this patient population. In fact, progression-free survival rates of 30% at 6 months may be expected using one of several dose-intensified temozolomide regimens [30, 31]. Interestingly, a British trial in recurrent, temozolomide-naïve malignant glioma patients failed to confirm a superiority of a dose-intensified over conventionally-dosed temozolomide regimen [32].
Bevacizumab has been approved for the treatment of recurrent glioblastoma in various countries including USA and Switzerland, but not in the European Union. The approval was based on two prospective trials that reported radiological response rates of 30% or more and promising progression-free and overall survival times, but did not include a bevacizumab-free control arm [33, 34]. The value of bevacizumab in the management of malignant gliomas is universally accepted, but many questions remain regarding timing and dosing schedules.
Current trials
Results from the largest glioblastoma trial ever performed, RTOG 0525, on dose-intensified temozolomide in newly diagnosed glioblastoma will be presented at the ASCO meeting in June 2011. Based on promising phase II data, two inhibitors of angiogenesis, bevacizumab [35] and cilengitide [36], have been evaluated in phase III registration trials in patients with newly diagnosed glioblastoma. The AVAGlio trial administered bevacizumab to all glioblastoma patients, whereas the CENTRIC trial on cilengitide restricted inclusion to resected patients with MGMT promoter methylation, based on the preferential benefit seen in this patient population in the phase II trial [36]. Both trials have completed enrolment, but results will not be available for some time. Meanwhile, there is renewed interest in immunotherapy with a randomised vaccination trial for glioblastoma patients carrying a specific mutation of the epidermal growth factor receptor (EGFR), EGFRvIII [37]. Whether a large trial using this complex treatment approach will be feasible is unclear at present. Moreover, there are many novel agents which are presently being explored in exploratory, mostly phase I/II trials in the recurrent setting.
Monitoring treatment response and course of disease
Neuroimaging is the primary monitoring tool for brain tumour patients, with MRI as the method of choice. MRI is usually done in 2–3 month intervals during treatment, but intervals can be prolonged during longer treatment- and disease progression-free periods, notably in patients with anaplastic gliomas. The introduction of anti-angiogenic agents into the management of malignant gliomas has necessitated a revision of the traditional criteria [38], which relied heavily on contrast enhancement. Since contrast enhancement is mediated in part by VEGF, accordingly the efficacy of VEGF antagonists will be overestimated by criteria that do not consider T2–weighted and fluid-attenuated inversion recovery (FLAIR) sequences [39].
Pseudoprogression refers to an apparent increase in the size of the contrast-enhancing lesion that does not reflect tumour progression, but rather treatment-related reactive changes. It is often claimed to be related to combined modality treatment of malignant gliomas [40], but can be seen after radiotherapy alone. Its frequency and clinical significance are difficult to estimate since temozolomide is usually continued in patients who are clinically stable or improved, but whose MRI scans appear to indicate progressive disease. This practice is reasonable, but precludes differentiation of pseudoprogression from delayed responses to temozolomide.
The role of other imaging modalities, including single photon emission-computed tomography (SPECT), positron emission tomography (PET), MR spectroscopy and functional MRI is currently being explored. In particular, amino acid PET is increasingly being used to identify hot spots indicative of malignant foci within extensive lesions and to define target volumes for radiotherapy.
EEG has a limited role in monitoring symptomatic epilepsy in brain tumour patients, but not to monitor disease progression. Serum biomarkers currently play no role in the follow-up of malignant glioma patients.
Symptomatic treatment and supportive care
Symptomatic treatment measures are of central importance in the management of malignant glioma patients. Corticosteroids are very effective in controlling tumour-associated brain oedema, but they are also a major source of reduced quality of life in this patient population. Accordingly, they should always be given at the lowest dose possible, and every option to taper or discontinue steroids should be used.
Malignant glioma patients are at a high risk of thromboembolic complications, and pulmonary embolism is a common non-tumour-related death. Therefore, prophylactic heparin should be considered in patients at risk, and secondary prophylaxis with either fractionated heparin or coumarin is safe and effective and not associated with an unacceptable risk of tumour bleeding [41].
Approximately 50% of malignant glioma patients will experience at least one epileptic seizure during the course of their disease. Primary prophylaxis with anti-epileptic drugs in patients without seizure history is not indicated, but patients suffering seizures beyond the early postoperative period may require anti-epileptic drugs for life [42]. Traditional agents like phenobarbitone, phenytoin or carmazepine have largely been replaced by newer drugs with a superior safety, tolerability and interaction profile, notably levetiracetam and lamotrigine. The prognostic impact of the choice of anti-epileptic drug remains controversial. Analysis of the EORTC NCIC trial database suggested that valproid acid enhanced haematological toxicity, but improved overall survival specifically in temozolomide-treated patients [43]. It is tempting to speculate that the histone deacetylase (HDAC) inhibitory activity of valproid acid contributed to this effect. Phase II trials using more potent HDAC inhibitors such as vorinostat are ongoing.
Given the overall improved outcome of malignant glioma patients, the need for neurorehabilitative measures should be constantly assessed. Finally, depression is a common, probably under recognised and under-treated condition in malignant glioma patients, and, as the disease evolves and becomes dominant in the life of patients and their caregivers, psychological and psycho-oncological support should be offered to all patients and their relatives.
Funding / potential competing interests: The author received honoraria for advisory boards and lectures as well as research support from MSD (Schering Plough), Merck Serono and Roche.
References
1 Louis DN, Ohgaki H, Wiestler OD, Cavenee WK, Burger PC, Jouvet A, et al. The 2007 WHO classification of tumours of the central nervous system. Acta Neuropathol. 2007;114:97–109.
2 Tabatabai G, Stupp R, van den Bent MJ, Hegi ME, Tonn JC, Wick W, Weller M. Molecular diagnostics of gliomas: the clinical perspective. Acta Neuropathol. 2010;120:585–92.
3 Griffin CA, Burger P, Morsberger L, Yonescu R, Swierczynski S, Weingart JD, et al. Identification of der(1;19)(q10;p10) in five oligodendrogliomas suggests mechanism of concurrent 1p and 19q loss. J Neuropathol Exp Neurol 2006;65:988–94.
4 Jenkins RB, Blair H, Ballman KV, Giannini C, Arusell RM, Law M, et al. A t(1;19)(q10;p10) mediates the combined deletions of 1p and 19q and predicts a better prognosis of patients with oligodendroglioma. Cancer Res 2006;66:9852–61.
5 Weller M, Stupp R, Reifenberger G, Brandes AA, Van den Bent MJ, Wick W, et al. MGMT promoter methylation in malignant gliomas: ready for personalized medicine? Nature Rev Neurol. 2010;6:39–51.
6 Yan H, Parsons DW, Jin G, McLendon R, Rasheed BA, Yuan W, et al. IDH1 and IDH2 mutations in gliomas. N Engl J Med. 2009;360:765–73.
7 Hartmann C, Hentschel B, Wick W, Capper D, Felsberg J, Simon M, et al. Patients with IDH1 wild type anaplastic astroctytomas exhibit worse prognosis than IDH1–mutated glioblastomas, and IDH1 mutation status accounts for the unfavorable prognostic effect of higher age: implications for classification of gliomas. Acta Neuropathol 2010;120:707–18.
8 Weller M, Wick W, von Deimling A. Isocitrate dehydrogenase mutations: a challenge to traditional views on the genesis and malignant progression of gliomas. Glia. In press.
9 Medical Research Council Brain Tumor Working Party. Randomized trial of procarbazine, lomustine, and vincristine in the adjuvant treatment of high-grade astrocytoma: A Medical Research Council Trial. J Clin Oncol. 2001;19:509–18.
10 Van den Bent, MJ, Carpentier AF, Brandes AA, Sanson M, Taphoorn M, Bernsen H, et al. Adjuvant procarbazine, lomustine, and vincristine improves progression-free survival but not overall survival in newly diagnosed anaplastic oligodendrogliomas and oligoastrocytomas: a randomized European Organisation for Research and Treatment of Cancer phase III trial. J Clin Oncol. 2006;24:2715–22.
11 Cairncross JG, Berkey B, Shaw E, Jenkins R, Scheithauer B, Brachman D, et al. Phase III trial of chemotherapy plus radiotherapy compared with radiotherapy alone for pure and mixed anaplastic oligodendroglioma: Intergroup Radiation Therapy Oncology Group Trial 9402. J Clin Oncol 2006;24:2707–14.
12 Wick W, Hartmann C, Engel C, Stoffels M, Felsberg J, Stockhammer F, et al. NOA-04 randomized phase III trial of sequential radiochemotherapy of anaplastic glioma with PCV or temozolomide. J Clin Oncol. 2009;27:5874–5880.
13 Van den Bent MJ, Dubbink HJ, Sanson M, van der Lee-Haarloo CR, Hegi M, Jeuken JW, et al. MGMT promoter methylation is prognostic but not predictive for outcome to adjuvant PCV chemotherapy in anaplastic oligodendroglial tumors: a report from EORTC Brain Tumor Group study 26951. J Clin Oncol. 2009;27:5881–6.
14 Van den Bent MJ, Dubbink HJ, Marie Y, Brandes AA, Taphoorn MJ, Wesseling P, et al. IDH1 and IDH2 mutations are prognostic but not predictive for outcome in anaplastic oligodendroglial tumors: a report of the European Organization for Research and Treatment of Cancer Brain Tumor Group. Clin Cancer Res. 2010;16:1597–1604.
15 Chamberlain MC, Johnston S. Salvage chemotherapy with bevacizumab for recurrent alkylator-refractory anaplastic astrocytoma. J Neurooncol. 2009;91:359–367.
16 Chamberlain MC, Johnston S. Bevacizumab for recurrent alkylator-refractory anaplastic oligodendroglioma. Cancer. 2009;115:1734–43.
17 Stupp R, Mason WP, van den Bent MJ, Weller M, Fisher B, Taphoorn MJB, et al. Radiotherapy plus concomitant and adjuvant temozolomide for patients with newly diagnosed glioblastoma. N Engl J Med. 2005;352:987–96.
18 Stummer W, Pichlmeier U, Meinel T, Wiestler OD, Zanella F, Reulen HJ. Fluorescence-guided surgery with 5–aminolevulinic acid for resection of malignant glioma: a randomised controlled multicentre phase III trial. Lancet Oncol. 2006;7:392–401.
19 Stupp R, Hegi ME, Mason WP, Van den Bent MJ, Taphoorn MJB, Janzer RC, et al. Effects of radiotherapy with concomitant and adjuvant temozolomide versus radiotherapy alone on survival in glioblastoma in a randomised phase III study: 5–year analysis of the EORTC-NCIC trial. Lancet Oncol. 2009;10:459–66.
20 Hegi ME, Diserens AC, Gorlia T, Hamou MF, de Tribolet N, Weller M, et al. MGMT gene silencing and response to temozolomide in glioblastoma. N Engl J Med. 2005;352:997–1003.
21 Westphal M, Hilt DC, Bortey E, Delavault P, Olivares R, Warnke P, et al. A phase 3 trial of local chemotherapy with biodegradable wafers (Gliadel wafers) in patients with primary malignant glioma. Neuro-Oncology 2003;5:79–88.
22 Keime-Guibert F, Chinot O, Taillandier L, Cartalat-Carel S, Frenay M, Kantor G, et al. Radiotherapy for glioblastoma in the elderly. N Engl J Med. 2007;356:1527–35.
23 Roa W, Brasher PM, Bauman G, et al. Abbreviated course of radiation therapy in older patients with glioblastoma multiforme: a prospective randomized clinical trial. J Clin Oncol. 2004;22:1583–8.
24 Malmstrom A, Grønberg BH, Stupp R, Marosi C, Frappaz D, Schultz HP, et al. Glioblastoma (GBM) in elderly patients: A randomized phase III trial comparing survival in patients treated with 6–week radiotherapy (RT) versus hypofractionated RT over 2 weeks versus temozolomide single-agent chemotherapy (TMZ). J Clin Oncol. 2010;28:7s (suppl; abstr LBA2002).
25 Wick W, Engel C, Combs SE, Nikkhah G, Steinbach J, Kortmann R, et al. NOA-08 randomized phase III trial of 1–week-on/1–week-off temozolomide versus involved field radiotherapy in elderly (older than age 65) patients with newly diagnosed anaplastic astrocytoma or glioblastoma (Methusalem). J Clin Oncol. 2010;28:7s (suppl; abstr LBA2001).
26 Weller M, Hentschel B, Felsberg J, Schackert G, Simon M, Tonn JC, et al. Profound predictive impact of MGMT promoter methylation in glioblastoma of the elderly. J Clin Oncol. 2011;XX:Xs (suppl.). In press.
27 Van den Bent MJ, Brandes AA, Rampling R, Kouwenhoven MCM, Kros JM, Carpentier AF, et al. Randomized phase II trial of erlotinib versus temozolomide or carmustine in recurrent glioblastoma: EORTC brain tumor group study 26034. J Clin Oncol 2009;27:1268–74.
28 Wick W, Puduvalli VK, Chamberlain M, Van den Bent M, Carpentier AF, Cher LM, et al. Enzastaurin versus lomustine in the treatment of recurrent intracranial glioblastoma: A phase III study. J Clin Oncol. 2010;28:1168–74.
29 Batchelor TT, Mulholland P, Neyns B, Nabors LB, Campone M, Wick A, et al. A phase III randomized study comparing the efficacy of cediranib as monotherapy, and in combination with lomustine, with lomustine alone in recurrent glioblastoma patients. European Society of Medical Oncology, Milano, Italy, 2010, LBA7.
30 Wick A, Pascher C, Wick W, Jauch T, Weller M, Bogdahn U, et al. Rechallenge with temozolomide in patients with recurrent gliomas. J Neurol 2009;256:734–41.
31 Perry JR, Belanger K, Mason WP, Fulton D, Kavan P, Easaw J, et al. Phase II trial of continuous dose-intense temozolomide in recurrent malignant glioma: RESCUE study. J Clin Oncol. 2010;28:2051–7.
32 Brada M, Stenning S, Gabe R, Thompson LC, Levy D, Rampling R, et al. Temozolomide versus procarbazine, lomustine, and vincristine in recurrent high-grade glioma. J Clin Oncol. 2010;28:4601–8.
33 Friedman H, Prados M, Wen P, Mikkelsen T, Schiff D, Abrey L, et al. Bevacizumab alone and in combination with irinotecan in recurrent glioblastoma. J Clin Oncol. 2009;27:4733–40.
34 Kreisl TN, Kim L, Moore K, Duic P, Royce C, Stroud I, et al. Phase II trial of single-agent bevacizumab followed by bevacizumab plus irinotecan at tumor progression in recurrent glioblastoma. J Clin Oncol. 2009;27:740–5.
35 Lai A, Tran A, Nghiemphu PL, Pope WB, Solis OE, Selch M, et al. Phase II study of bevacizumab plus temozolomide during and after radiation therapy for patients with newly diagnosed glioblastoma multiforme. J Clin Oncol. 2011;29:142–8.
36 Stupp R, Hegi ME, Neyns B, Goldbrunner R, Schlegel U, Clement PMJ, et al. Phase I//IIa study of cilengitide and temozolomide with concomitant radiotherapy followed by cilengitide and temozolomide maintenance therapy in patients with newly diagnosed glioblastoma. J Clin Oncol. 2010;28:2712–8.
37 Sampson JH, Heimberger AB, Archer GE, Aldape KD, Friedman AH, Friedman HS, et al. Immunologic escape after prolonged progression-free survival with epidermal growth factor receptor variant III peptide vaccination in patients with newly diagnosed glioblastoma. J Clin Oncol. 2010;28:4722–9.
38 Macdonald D, Cascino T, Schold SJ, Cairncross JG. Response criteria for phase II studies of supratentorial malignant glioma. J Clin Oncol 1990;8:1277–80.
39 Wen PY, Macdonald DR, Reardon DA, Cloughesy TF, Sorensen AG, Galanis E, et al. Updated response assessment criteria for high-grade gliomas: response assessment in neuro-oncology working group. J Clin Oncol. 2010;28:1963–72.
40 Brandsma D, Stalpers L, Taal W, Sminia P, Van den Bent MJ. Clinical features, mechanisms, and management of pseudoprogression in malignant gliomas. Lancet Oncology. 2008;9:453–61.
41 Perry JR, Julian JA, Laperierre NJ, Geerts W, Agnelli G, Rogers LR, et al. PRODIGE: a randomized placebo-controlled trial of dalteparin low-molecular-weight heparin thromboprophylaxis in patients with newly diagnosed malignant glioma. J Thromb Haemostas. 2010;8:1959–65.
42 Van Breemen MS, Wilms EB, Vecht CJ. Epilepsy in patients with brain tumours: epidemiology, mechanisms, and management. Lancet Neurol. 2007;6:421–30.
43 Weller M, Gorlia T, Cairncross JG, Van den Bent MJ, Mason W, Belanger K, et al. Does valproic acid improve outcome in glioblastoma? An analysis of the EORTC/NCIC temozolomide trial. Neurology. In press.